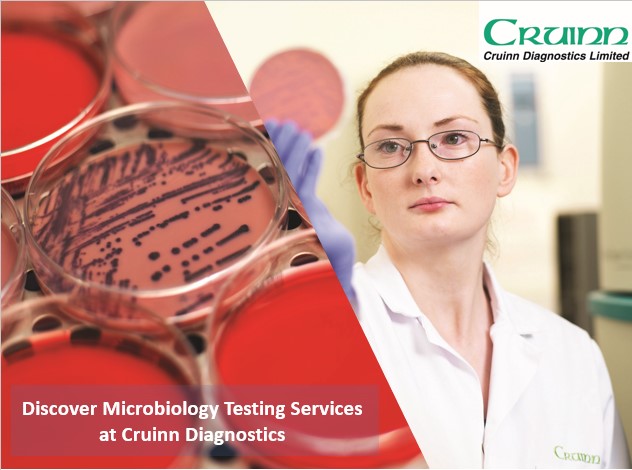
Did you know that Cruinn perform Environmental Monitoring of Cleanrooms,IVF Clinics &amp; Laboratories?

Air Samples, Settle Plates, Contact Plates, Swab Analysis, Particle Counts
Microbial Identifications
Media Growth Promotion

Contact: +353 1 6297400 / cruinnqualitygroup@cruinn.ie

Cruinn Diagnostics
@cruinndiag
Leading Providers to Laboratory and Healthcare Professionals in Ireland
#Laboratory #Diagnostics #Calibration
ID: 984089324835758080
http://www.cruinndiagnostics.ie/ 11-04-2018 15:22:33
161 Tweet
124 Followers
233 Following




The Pancreatic Stone Protein (PSP) point-of-care test on the Abionic_EN abioSCOPE® enables the earliest detection of sepsis in just 5 mins. The PSP biomarker allows for the detection of sepsis up to 72hrs earlier than conventional sepsis markers. For info contact [email protected]


Proven Lab-grade Results: 5 part diff CBC results with 19 parameters & sophisticated flagging capabilities, for point of care testing. The 1st CBC analyzer cleared for blood taken directly from either a finger prick or a venous sample. For more info, contact [email protected]


Your personal tabletop lab freezer from Nordic Lab, ULT U35. The small footprint allows you to put your samples right next to your workstation, making it ideal for users who frequently need sample access & require quick temperature recovery. For more, contact: [email protected]


We are offering discounted prices at the moment on Siemens Covid antigen test kits - see pricing below and contact [email protected] for further details.


Did you know that Cruinn perform Environmental Monitoring of Cleanrooms,IVF Clinics & Laboratories? Air Samples, Settle Plates, Contact Plates, Swab Analysis, Particle Counts Microbial Identifications Media Growth Promotion Contact: +353 1 6297400 / [email protected]

Cruinn will be attending the University College Dublin Conway Festival of Research & Innovation both tomorrow and Friday, showing a range of small laboratory equipment & consumables from all of our quality suppliers.Drop by to meet our Sales team - there may even be a few freebies involved!😃




We are delighted to sponsor & exhibit at the PDA Ireland Contract Manufacturing event in Cork next week. We hope to see you there! CONTRACT MANUFACTURING - Achieving & Maintaining a Successful Partnership 📍 Radisson Blu, Little Island,Cork 📆 Thurs 29th Feb ⌛ 8am – 4pm





A huge thank you to all the vendors who generously sponsored Chemistry Day 2024. Your support helps make events like this possible! abcr GmbH_Gute Chemie Anton Paar Avantor Cruinn Diagnostics Fluorochem Ltd GPE Scientific Ltd Mason Technology Ltd Lab Unlimited Scientific Laboratory Supplies (SLS) #ChemistryDay












